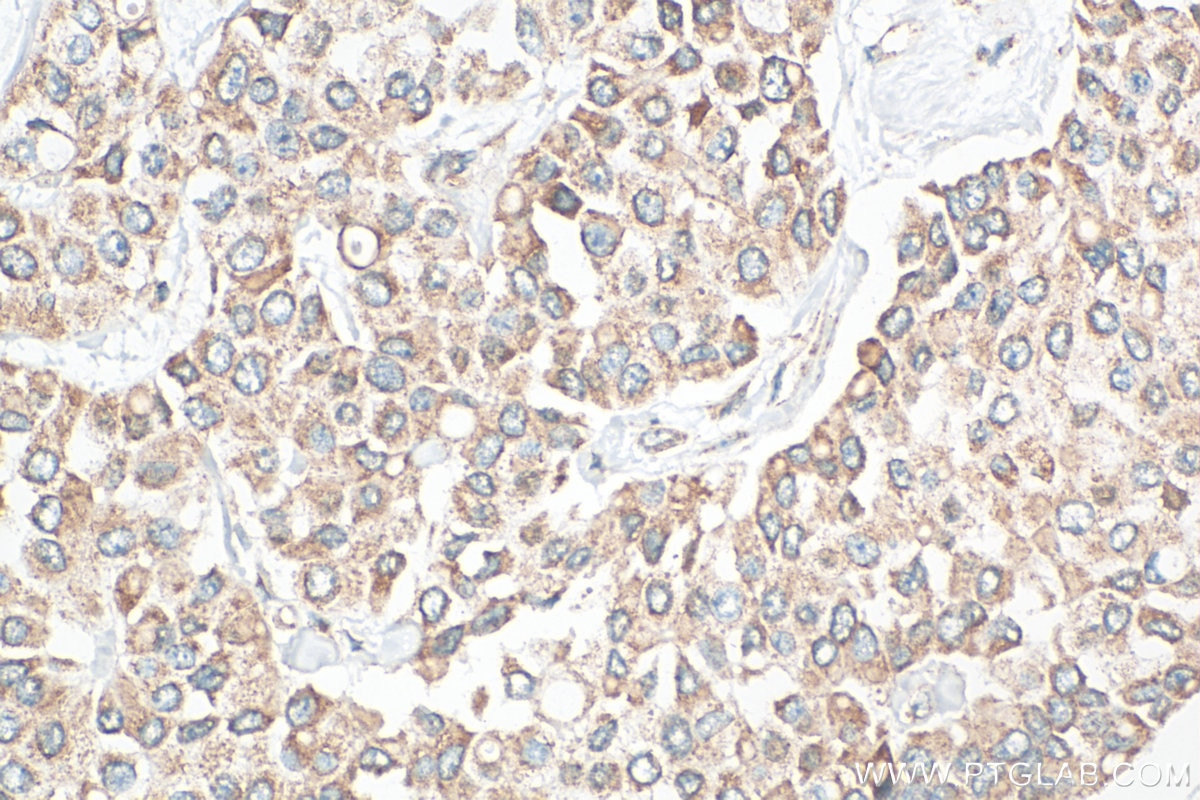
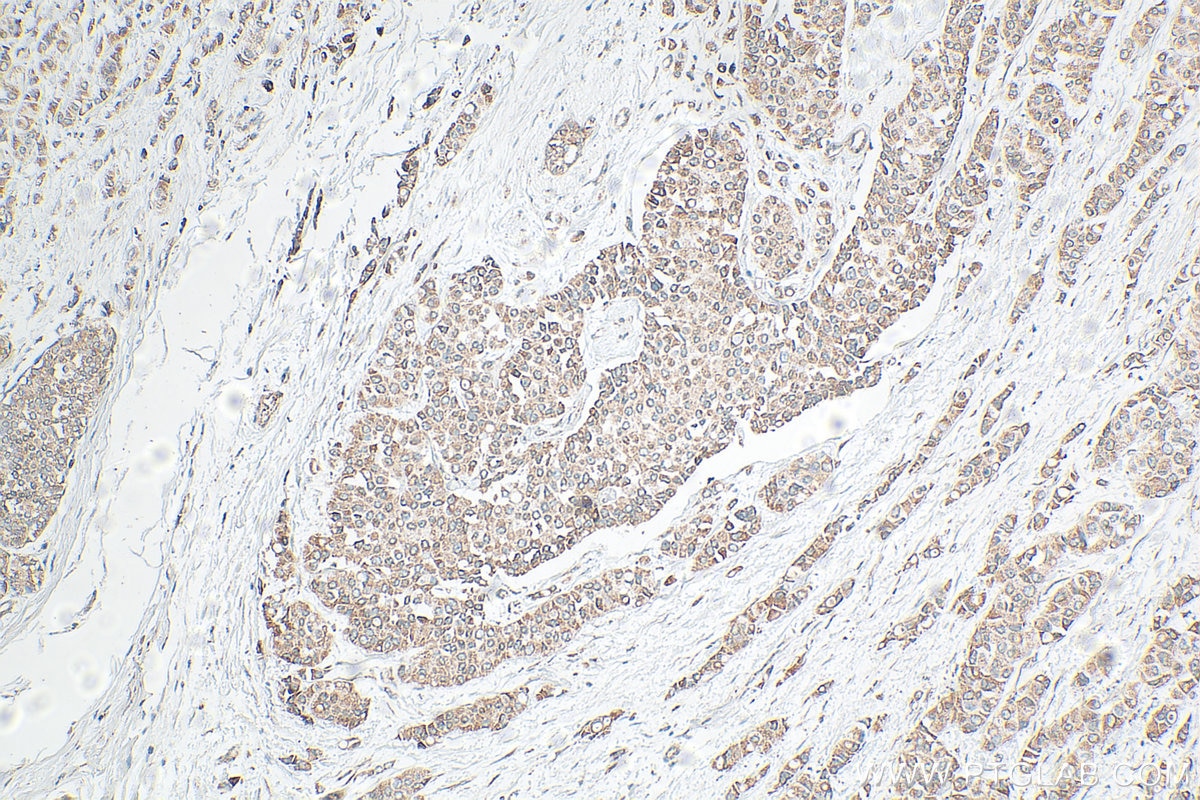

Tested Applications
| Positive WB detected in | HeLa cells, K-562 cells, mouse lung tissue, MCF-7 cells, MDA-MB-231 cells |
| Positive IHC detected in | human breast cancer tissue Note: suggested antigen retrieval with TE buffer pH 9.0; (*) Alternatively, antigen retrieval may be performed with citrate buffer pH 6.0 |
| Positive IF/ICC detected in | HeLa cells |
Recommended dilution
| Application | Dilution |
|---|---|
| Western Blot (WB) | WB : 1:500-1:1000 |
| Immunohistochemistry (IHC) | IHC : 1:200-1:800 |
| Immunofluorescence (IF)/ICC | IF/ICC : 1:50-1:500 |
| It is recommended that this reagent should be titrated in each testing system to obtain optimal results. | |
| Sample-dependent, Check data in validation data gallery. | |
Published Applications
| KD/KO | See 1 publications below |
| WB | See 49 publications below |
| IHC | See 14 publications below |
| IF | See 7 publications below |
| CoIP | See 1 publications below |
Product Information
19999-1-AP targets TGF beta 2-Specific in WB, IHC, IF/ICC, CoIP, ELISA applications and shows reactivity with human, mouse samples.
| Tested Reactivity | human, mouse |
| Cited Reactivity | human, mouse, rat, bovine |
| Host / Isotype | Rabbit / IgG |
| Class | Polyclonal |
| Type | Antibody |
| Immunogen |
Peptide Predict reactive species |
| Full Name | transforming growth factor, beta 2 |
| Calculated Molecular Weight | 48 kDa |
| Observed Molecular Weight | 48 kDa |
| GenBank Accession Number | NM_003238 |
| Gene Symbol | TGFB2 |
| Gene ID (NCBI) | 7042 |
| RRID | AB_10646467 |
| Conjugate | Unconjugated |
| Form | Liquid |
| Purification Method | Antigen affinity purification |
| UNIPROT ID | P61812 |
| Storage Buffer | PBS with 0.02% sodium azide and 50% glycerol, pH 7.3. |
| Storage Conditions | Store at -20°C. Stable for one year after shipment. Aliquoting is unnecessary for -20oC storage. 20ul sizes contain 0.1% BSA. |
Background Information
Tranforming growth factor beta-2 (TGFB2), also named G-TSF, BSC-1 cell growth inhibitor, Polyergin and Cetermin, belongs to the TGF-beta family. TGFB2 is a secreted protein and contains a 19aa signal peptides at its N-terminal. Heterodimers with TGFB1 and with TGFB2 have been found in bone. It was proved to have suppressive effects on interleukin-2 dependent T-cell growth. This antibody is TGFB2 specific not detecting other TGFBs.
Protocols
| Product Specific Protocols | |
|---|---|
| IF protocol for TGF beta 2-Specific antibody 19999-1-AP | Download protocol |
| IHC protocol for TGF beta 2-Specific antibody 19999-1-AP | Download protocol |
| WB protocol for TGF beta 2-Specific antibody 19999-1-AP | Download protocol |
| Standard Protocols | |
|---|---|
| Click here to view our Standard Protocols |
Publications
| Species | Application | Title |
|---|---|---|
ACS Nano Gold Nanoparticles Induce Tumor Vessel Normalization and Impair Metastasis by Inhibiting Endothelial Smad2/3 Signaling. | ||
Cancer Res Osteoblast-secreted factors mediate dormancy of metastatic prostate cancer in the bone via activation of the TGFβRIII-p38MAPK-pS249/T252RB pathway.
| ||
Cell Death Differ USP9X-mediated KDM4C deubiquitination promotes lung cancer radioresistance by epigenetically inducing TGF-β2 transcription. | ||
Dev Cell Endothelial-to-Osteoblast Conversion Generates Osteoblastic Metastasis of Prostate Cancer. | ||
Cancer Res SIX1 promotes tumor lymphangiogenesis by coordinating TGFβ signals that increase expression of VEGF-C. | ||
Cancer Lett ZEB1 represses biogenesis of circ-DOCK5 to facilitate metastasis in esophageal squamous cell carcinoma via a positive feedback loop with TGF-β. |
Reviews
The reviews below have been submitted by verified Proteintech customers who received an incentive for providing their feedback.
FH Aline Seiko (Verified Customer) (05-12-2025) | It was observed a clear expression of the protein in the expected molecular weight of 48kDa, but also for the spleen it was observed a monomer isoform of 12kDa.
|
FH Kazu (Verified Customer) (12-14-2022) | A clear, single band at the expected molecular weight was observed by western blotting.
|